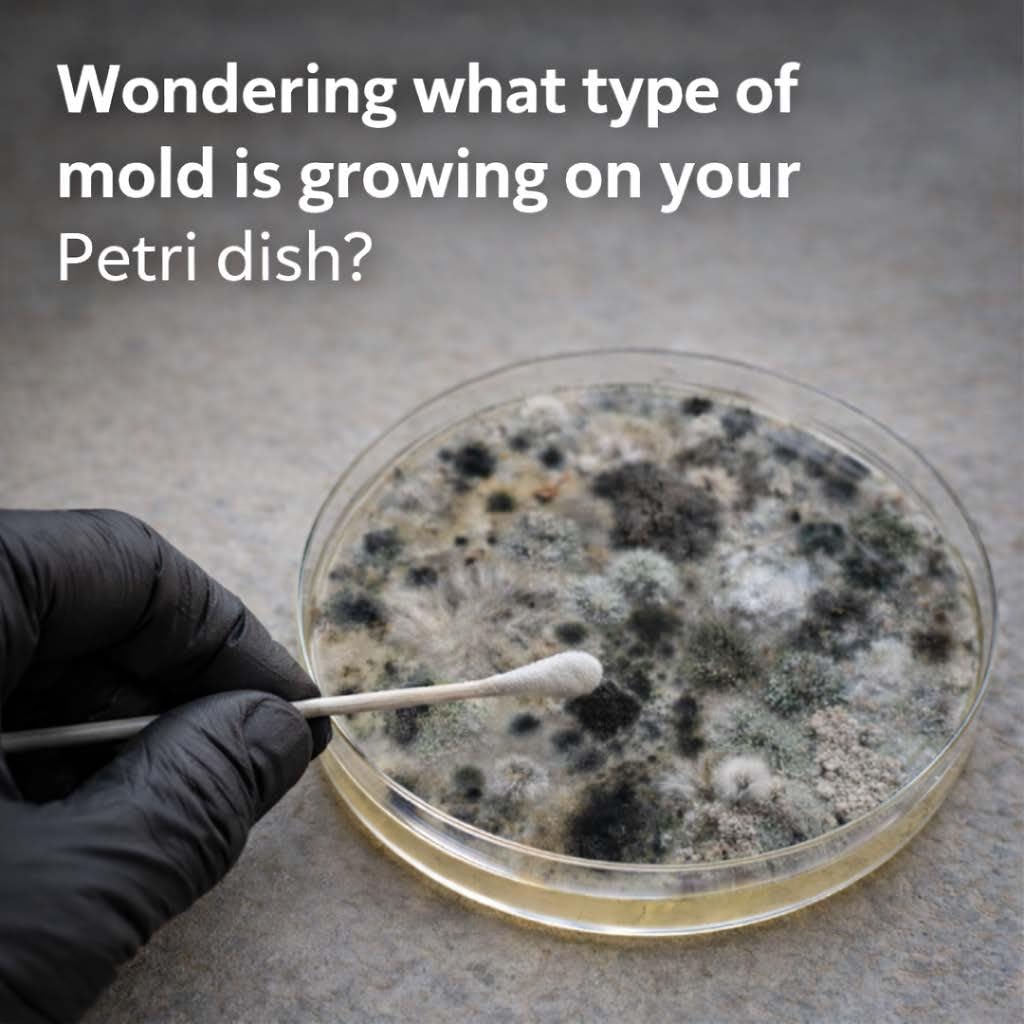
Mold Test Kit – Lab Fees Included, Detects 20+ Mold Types & Pollen, Easy-to-Use Guide, Professional-Grade Testing (2 Pack)

Mold Test Kit – Lab Fees Included, Detects 20+ Mold Types & Pollen, Easy-to-Use Guide, Professional-Grade Testing (2 Pack)
$85.95
Price when purchased online
Free shipping
Free 30-day returns
Sold and shipped by mtbfirstaid.com.au
We aim to show you accurate product information. Manufacturers, suppliers and others provide what you see here.
$85.95
Price when purchased online
Free shipping
Free 30-day returns
Sold and shipped by mtbfirstaid.com.au
Free 30-day returns Details
Product details
| Management number | 210959436 | Release Date | 2026/04/04 | List Price | $34.38 | Model Number | 210959436 | ||
|---|---|---|---|---|---|---|---|---|---|
| Category | |||||||||
- Tests for multiple mold types found on household surfaces and vents; samples analyzed by a certified laboratory for accurate results
- Lab Fees Included: No surprise costs, our price covers lab testing for your mold sample. After collecting your sample, send it to our certified lab using mail courier of your choice.
- Made in the USA by a team experienced in mold testing
- Includes a mold inspection manual with images and descriptions of common mold types for easy comparison with lab results.
- Kit Includes: Swab, gloves, return envelope to shipt to a certified lab, and a detailed inspection guide to identify mold-prone areas, plus a lab results report.


| Item Weight | 1.76 ounces |
|---|---|
| Manufacturer | Teton Environmental Inc |
| Product Dimensions | 11.5 x 8 x 0.5 inches |
Correction of product information
If you notice any omissions or errors in the product information on this page, please use the correction request form below.
Correction Request Form